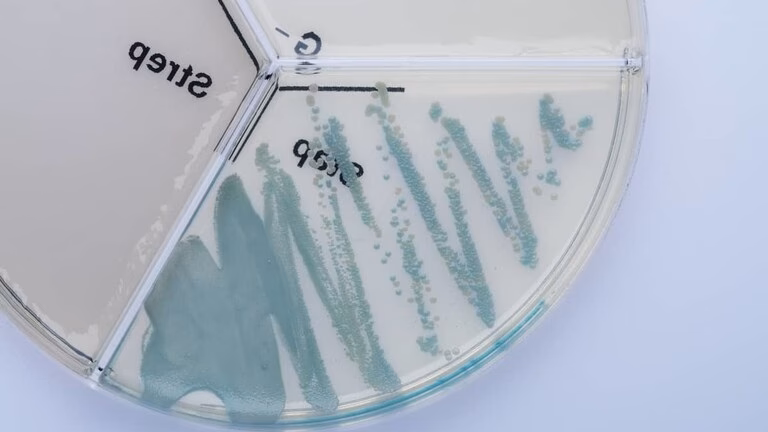
What is the effective publication of Staphylococcus xylosus?

17/07/2025
Staphylococcus xylosus er en fascinerende og alsidig bakterie, der tilhører gruppen af koagulase-negative stafylokokker. Den blev først isoleret fra menneskehud, men findes langt mere almindeligt på huden og slimhinderne hos dyr, især pattedyr som husdyr. Denne tætte tilknytning til dyr forklarer dens hyppige tilstedeværelse i kød og kødprodukter. Mens den spiller en afgørende og positiv rolle i fødevareindustrien, især inden for produktion af fermenterede pølser og tørrede kødprodukter, er den også anerkendt som et potentielt humant patogen. Denne dobbelte natur gør S. xylosus til et emne af stor interesse for både fødevareteknologer og sundhedsprofessionelle. Forståelsen af dens biologi, metabolisme og interaktion med omgivelserne er nøglen til at udnytte dens fordele og håndtere dens risici.

Den Videnskabelige Opdagelse og Klassifikation
Den formelle anerkendelse og navngivning af Staphylococcus xylosus fandt sted i 1975. Den effektive publikation, der etablerede den som en ny art, blev udgivet af K.H. Schleifer og W.E. Kloos i International Journal of Systematic Bacteriology. Artiklen bar titlen "Isolation and characterization of staphylococci from human skin. I. Amended descriptions of Staphylococcus epidermidis and Staphylococcus saprophyticus and descriptions of three new species: Staphylococcus cohnii, Staphylococcus haemolyticus, and Staphylococcus xylosus."
Navnet xylosus stammer fra det latinske "xylosus", der betyder "hørende til xylose", hvilket sandsynligvis henviser til bakteriens evne til at metabolisere denne type sukker. Dens type stamme, som er den referenceprøve, der definerer arten, er kendt under flere betegnelser i forskellige kultursamlinger, herunder ATCC 29971 og DSM 20266. Bakterien er validt publiceret under ICNP (International Code of Nomenclature of Prokaryotes) og betragtes som det korrekte taksonomiske navn. Den er endda eksplicit anbefalet til medicinsk brug og er opført på "List of Recommended Names for bacteria of medical importance (LoRN)", primært på grund af dens anerkendte risikogruppe.
Rollen i Fødevareproduktion: En Uundværlig Hjælper
Staphylococcus xylosus er en sand stjerne i produktionen af fermenterede og saltede kødprodukter. Den anvendes ofte som en startkultur i fremstillingen af pølser, hvor den spiller en central rolle i udviklingen af produktets endelige kvalitet. Dens tilpasningsevne til kødsubstratet og de forskellige processer som saltning, tørring og fermentering gør den ekstremt effektiv.
Bakteriens bidrag til kødprodukter er mangefacetteret:
- Farveudvikling: En af de mest kritiske funktioner er dens nitratreduktase-aktivitet. Den omdanner nitrat, der tilsættes kødet, til nitrit. Nitrit reagerer derefter med myoglobin i kødet og danner nitrosomyoglobin, som giver den karakteristiske stabile, røde farve i saltede kødprodukter som salami og skinke.
- Smags- og Aromaudvikling: Gennem katabolisme af pyruvat og aminosyrer producerer S. xylosus en række flygtige, aromatiske forbindelser, der er afgørende for den komplekse smagsprofil i fermenterede pølser.
- Forebyggelse af Harskning: Bakterien begrænser oxidationen af fedtsyrer. Dette er afgørende for at forhindre harskning, som ellers ville give produktet en ubehagelig smag og lugt og forkorte holdbarheden.
Når S. xylosus tilsættes som en del af en startkultur, dominerer den ofte mikrofloraen gennem hele produktionsprocessen. Dette viser dens fremragende tilpasning til det specifikke miljø, der findes i kødprodukter, som er kendetegnet ved højt saltindhold, lav vandaktivitet og varierende pH.
Metabolisk Tilpasning til Kødsubstrater
S. xylosus' succes i kødprodukter skyldes dens sofistikerede metaboliske apparat, der gør den i stand til effektivt at udnytte de næringsstoffer, der er tilgængelige i kød. Genomiske studier, især af stammen C2a, har afsløret en imponerende genetisk kapacitet til at nedbryde både kulhydrater og proteiner.

Kulhydratmetabolisme
Selvom kød indeholder meget få kulhydrater, tilsættes sukkerarter som glukose, saccharose og laktose ofte til pølsefarsen for at fremme fermenteringen. S. xylosus er veludstyret til at transportere og katabolisere disse sukkerarter. Den bruger to hovedsystemer til sukker transport: det phosphoenolpyruvat-afhængige sukkerphosphotransferase-system (PTS) og PTS-uafhængige systemer. PTS-systemet er især effektivt ved lave sukkerkoncentrationer, mens det PTS-uafhængige system (via GlcU-permease) fungerer ved høje koncentrationer. Dette giver bakterien en fleksibilitet til at tilpasse sig forskellige sukker niveauer.
Tabel over Kulhydrattransport og -katabolisme i S. xylosus C2a
| System | Substrat | Nøgle-gener/proteiner |
|---|---|---|
| Phosphotransferase System (PTS) | Glukose, Saccharose, Fruktose, Mannitol | ptsG, ptsI, ptsH, scrA, fruA |
| PTS-Uafhængigt System | Glukose, Laktose, Galactose | glcU, glkA, lacP, lacH, galK, galE, galT |
| Anden katabolisme | Laktat | Laktatpermease, laktat-kinon oxidoreduktase |
Interessant nok kan S. xylosus i en kødmodel forbruge glukose og laktat (et naturligt forekommende stof i kød) samtidigt, hvilket optimerer dens energiproduktion.
Nitrogenmetabolisme
Kød består primært af proteiner. Mens S. xylosus' egen proteolytiske aktivitet er lav, er den yderst dygtig til at optage og nedbryde peptider (korte kæder af aminosyrer), som frigives af kødets egne enzymer. Genomet af S. xylosus C2a indeholder mindst to systemer til transport af oligopeptider og over 20 gener, der koder for peptidaser, enzymer der spalter peptider til frie aminosyrer. Disse aminosyrer kan derefter bruges til bakteriens egen vækst eller nedbrydes yderligere til aromatiske forbindelser. Arginin og glutamat, som findes i rigelige mængder i kød, er vigtige energikilder for bakterien, især når de foretrukne kulhydratkilder er opbrugt.
Sundhedsmæssige Overvejelser og Risikovurdering
På trods af dens gavnlige rolle i fødevarer, er Staphylococcus xylosus også anerkendt som en opportunistisk patogen. Ifølge en omfattende undersøgelse af Bartlett et al. (2022) er arten klassificeret som en etableret human patogen. Infektioner er dog relativt sjældne sammenlignet med mere kendte stafylokokker som Staphylococcus aureus. Den udgør primært en risiko for personer med svækket immunforsvar eller i forbindelse med medicinsk udstyr.
Den officielle risikogruppe-klassificering varierer internationalt, hvilket afspejler forskellige nationale vurderinger:
- Belgien: Risikogruppe 2 ("human and animal pathogen").
- Canada: Risikogruppe 1 ("Animal classification RG: 1").
- Schweiz: Risikogruppe 1.
- Tyskland: Risikogruppe 1.
Denne variation understreger vigtigheden af at følge lokale retningslinjer og regler. For fødevaresikkerheden er en vigtig bekymring produktionen af biogene aminer som histamin og tyramin, som kan forårsage negative helbredsreaktioner hos følsomme individer. Mens nogle bakterier er kendte producenter, har studier af S. xylosus-stammer isoleret fra spanske tørrede pølser vist, at de ikke producerede tyramin, histamin eller andre problematiske aminer. Dette er en positiv egenskab for stammer, der anvendes som startkulturer, men det kan ikke generaliseres til alle stammer af arten.
Ofte Stillede Spørgsmål (FAQ)
Hvad er den effektive publikation af Staphylococcus xylosus?
Den effektive publikation er en videnskabelig artikel af Schleifer og Kloos fra 1975 i International Journal of Systematic Bacteriology, hvor arten for første gang blev formelt beskrevet og navngivet.
Er Staphylococcus xylosus farlig for mennesker?
S. xylosus betragtes som en opportunistisk patogen og er klassificeret som en etableret human patogen. Den forårsager sjældent sygdom hos raske mennesker, men kan forårsage infektioner hos personer med nedsat immunforsvar. I fødevarer, hvor den bruges som startkultur, anses den generelt for sikker, da produktionsprocesserne og konkurrencen fra andre mikroorganismer kontrollerer dens vækst.
Hvorfor bruges Staphylococcus xylosus i pølser?
Den bruges som en startkultur på grund af dens evne til at forbedre produktets kvalitet markant. Den bidrager til at udvikle den karakteristiske røde farve via nitratreduktion, skaber kompleks smag og aroma ved at nedbryde aminosyrer, og forhindrer harskning ved at beskytte fedtstofferne mod oxidation.
Producerer Staphylococcus xylosus tyramin?
Evnen til at producere biogene aminer som tyramin varierer mellem forskellige stammer. Mindst ét studie af stammer isoleret fra iberiske tørrede pølser viste, at de ikke producerede tyramin. Ved udvælgelse af stammer til brug som startkulturer er det et vigtigt kriterium at sikre, at de ikke producerer disse uønskede forbindelser.
Hvis du vil læse andre artikler, der ligner Staphylococcus xylosus: Viden om Bakterien, kan du besøge kategorien Sundhed.
